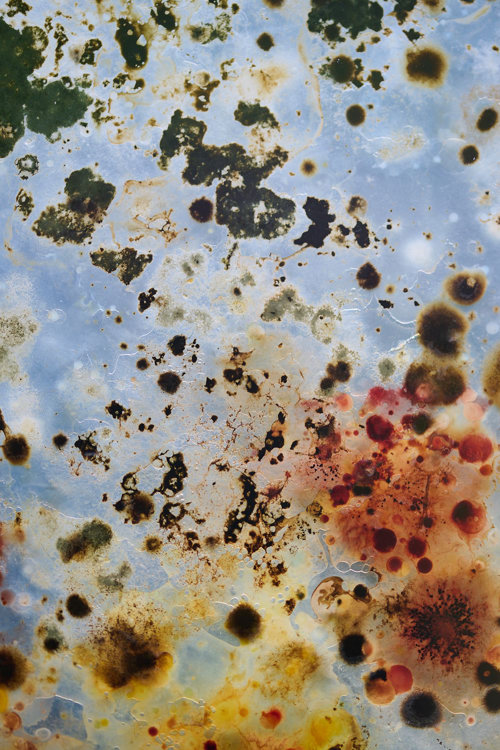
Microbial Dwellings - et midlertidigt værk på Harrild Hede af Rhoda Ting & Mikkel Bojesen

Rhoda Ting & Mikkel Bojesen
Værkerne Microbial Dwellings og Amongst Ruins af kunstnerne Rhoda Ting & Mikkel Bojesen og i samarbejde med Engesvang

Om Microbial Dwellings og Amongst Ruins
Til udstillingen Hedens Kunst vender kunstnergruppen Rhoda Ting & Mikkel Bojesen blikket mod det, vi normalt ikke kan se: mikroberne. Usynlige for det menneskelige øje, men uundværlige for de økosystemer, vi er en del af.
Microbial Dwellings består af to store petriskåle, hvor gær, bakterier og svampe vokser frem fra prøver af jord og vand indsamlet sammen med borgere ved Harrild Hede og i Engesvang. De små livsformer får her plads til at udfolde sig som en levende og foranderlig skulptur. Publikum inviteres til at betragte det mikroskopiske liv som både skønhed og proces: Hvad afslører den mikroskopiske biodiversitet? Og hvilke forbindelser og relationer bliver synlige, når vi ser naturen på denne måde og i denne skala?
I Engesvang præsenteres værket Amongst Ruins – et basrelief, en lav skulpturel overflade, skabt som afstøbning af mikrober indsamlet lokalt. Hvor Microbial Dwellings arbejder med levende organismer i konstant forandring, fastholder Amongst Ruins sporene i en fast og permanent form. Ruins i værkets titel antyder rester af noget forsvundet, men også noget tilbageværende med et nyt afsæt. De to værker står dermed i dialog: det levende og forgængelige ved siden af det aftryk, der bevares som et vidnesbyrd.
Med disse værker skabes et nyt perspektiv på sameksistens. Når vi bygger, opdyrker eller forsøger at gøre vores byrum ”grønne”, fortrænger vi ofte de mikroorganismer, som udgør grundlaget for andre livsformer. Værkerne stiller spørgsmål ved, hvordan vi kan genintroducere og sanse de skjulte livsformer – og dermed åbne for nye måder at leve sammen med naturen på.
“Vi forsøger at samskabe med andre end menneskelige arter og at synliggøre historier fra livet uden for det menneskelige blik. Ved at kombinere videnskab, teknologi og industri undersøger vi nye former for fremtider og måder at bevæge os positivt ud over det antropocæne.”
– Rhoda Ting & Mikkel Bojesen
Ved at bringe mikroberne i fokus minder Ting & Bojesen os om, at heden og jorden under os er fuld af liv, vi sjældent ser – men som vi samtidig er dybt afhængige af.
Om Rhoda Thing & Mikkel Bojesen
Ting & Bojesen arbejder mellem Melbourne og København. Deres praksis kombinerer kunst, økofilosofi og videnskab og søger at de-centrere det menneskelige perspektiv. De samskaber deres værker med svampe, mikrober, marine livsformer, flora og tidevand – altid med fokus på sameksistens og gensidig udvikling. Duoen har udstillet både i Danmark og internationalt; Light Art Museum (BU), Copenhagen Contemporary (DK), GLAS - Museet for glaskunst (DK), Kunsthal Aarhus (DK) og Art Sonje Center (KR). Blandt deres større projekter er Amphibiome (2024, Jøssingfjord Vitenmuseum, Norge) og Archetype (2022, Aabenraa Kommune). De har modtaget støtte fra Statens Kunstfond (2025) og været på residency ved European Marine Board (2023).
Læs mere om Rhoda Thing & Mikkel Bojesen på www.studiothinkinghand.com og på Instagram.

Fotograf: Robert Damisch

Rhoda Ting & Mikkel Bojesen
Født 1985, Australien - Født 1988, Danmark
Værker:
Harrild Hede:
Microbial Dwellings, 2025. Kartoffel-dextrose-agar, mikroorganismer dyrket fra sedimentprøver indsamlet ved Harrild Hede og i Engesvang, akryl, metal. (2 x) 50 x 60 x 4 cm.
Engesvang:
Amongst Ruins, 2025. Jesmonite og beton. Basrelief skabt som afstøbning af mikrober indsamlet fra Engesvang. 60 × 50 × 4 cm